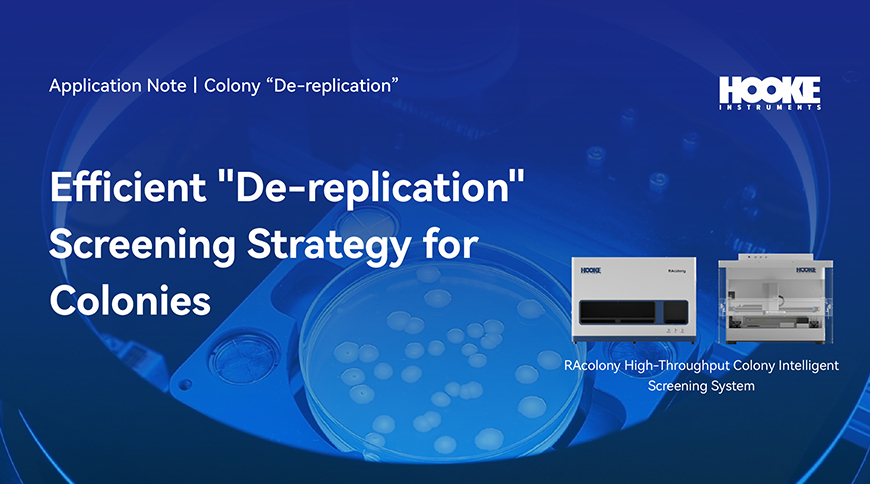
网站标题图.jpg
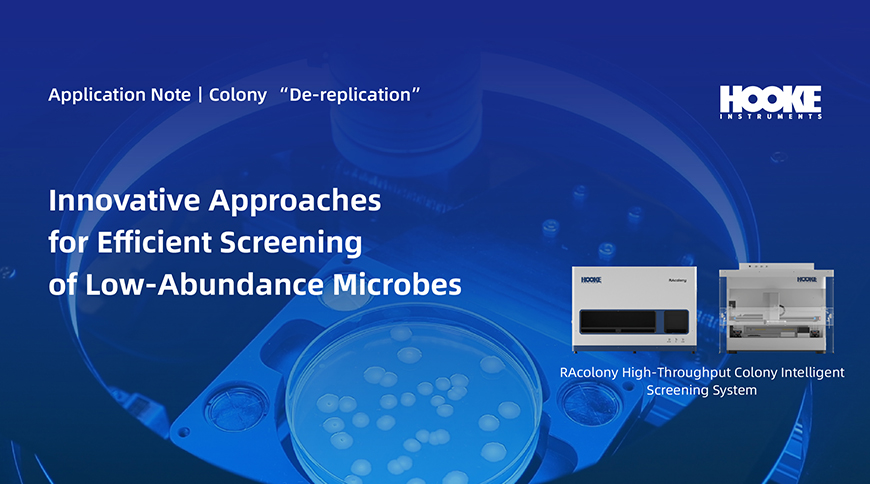
网站标题图.jpg

Single-Cell Sorter
Single Cell Optical Tweezers
High-Throughput Colony Intelligent Screening System
Confocal Raman Microscope
Ultrafast 3D Fluorescence Imaging System
Particle Analyzer
Microbiology
Medical Research
Microplastics
Biopharmaceuticals
Microecological Medcines
Fermentation Broth Testing
Show Results:
Clear
-

 Colony “De-replication”丨Efficient Screening of Microbial Strains from Environmental (Activated Sludge) Resources
Colony “De-replication”丨Efficient Screening of Microbial Strains from Environmental (Activated Sludge) ResourcesDownloads
-

 Single-Cell Sorting丨Novel Strategies for Agricultural Applications:Efficient Screening of Active Phosphate-Solubilizing Bacteria
Single-Cell Sorting丨Novel Strategies for Agricultural Applications:Efficient Screening of Active Phosphate-Solubilizing BacteriaDownloads
-

 Colony “De-replication”丨A New Strategy for Screening Glacier Strains in Extreme Environments
Colony “De-replication”丨A New Strategy for Screening Glacier Strains in Extreme EnvironmentsDownloads
-

 Raman Spectroscopy丨A New Approach to Studying Microplastic-Induced Damage in Animal Tissues
Raman Spectroscopy丨A New Approach to Studying Microplastic-Induced Damage in Animal TissuesDownloads
-

 Single-Cell Sorting丨Isolation, Cultivation, and Mechanistic Analysis of Methane-Dependent Complete Denitrifying Bacteria
Single-Cell Sorting丨Isolation, Cultivation, and Mechanistic Analysis of Methane-Dependent Complete Denitrifying BacteriaDownloads
-
Colony “De-replication”丨Efficient De-replication Screening Strategy for Colonies
Colony “De-replication”丨Efficient De-replication Screening Strategy for ColoniesDownloads
-

 Single Cell Sorting丨A Novel Strategy for Visualizing Horizontal Gene Transfer
Single Cell Sorting丨A Novel Strategy for Visualizing Horizontal Gene TransferDownloads
-

 Raman Spectroscopy丨Breaking the Detection Limits for Nanoplastics in Crops
Raman Spectroscopy丨Breaking the Detection Limits for Nanoplastics in CropsDownloads
-
Colony “De-replication”丨Innovative Approaches for Efficient Screening of Low-Abundance Microbes
Colony “De-replication”丨Innovative Approaches for Efficient Screening of Low-Abundance MicrobesDownloads
Learn More





